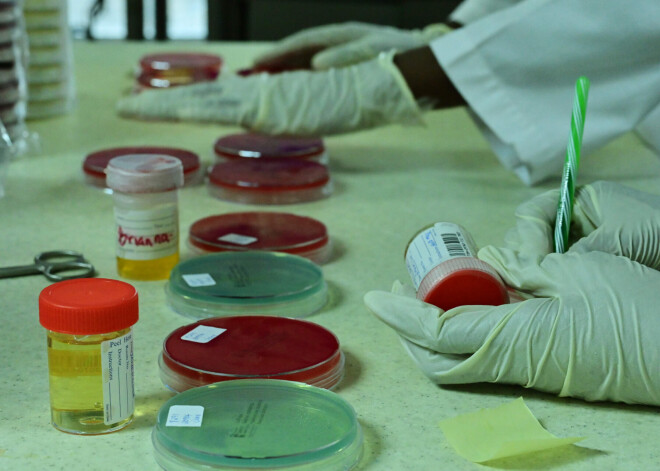
USADA mēģina veikt "virtuālu" testēšanu Covid-19 pandēmijas laikā

USADA mēģina veikt "virtuālu" testēšanu Covid-19 pandēmijas laikā
ASV Antidopinga aģentūra (USADA) ir nākusi klajā ar jauna veida analīžu pārbaudes programmu koronavīrusa pandēmijas apstākļos, veicot analīžu savākšanu attālināti, sestdien paziņoja USADA.
Tā kā ASV tāpat kā lielu daļu pasaules skārusi izolācija koronavīrusa dēļ, USADA ir uzsākusi programmu, kurā sportisti paši mājās savāc asins un urīna paraugus, vienlaikus attālināti tiekot novērotiem "Zoom" vai 'FaceTime" programmās.
Analīžu pārbaužu komplekti tiek nosūtīti sportistiem, kuriem pēc dopinga kontroles darbinieka negaidīta zvana jānodod analīzes.
USADA darbinieks vēro, kā tiek ņemti asins paraugi, bet urīna paraugi tiek ievākti privātā kārtā.
Paraugi tiek aizzīmogoti dopinga kontroles darbinieka acu priekšā un nosūtīti akreditētai laboratorijai pārbaudei.
USADA izpilddirektors Treviss Tigarts laikrakstam "The New York Times" sacīja, ka daudzas ASV olimpiskās cerības vēlas piedalīties šajā izmēģinājuma projektā.
Brīvā stila peldētāja Ketija Ledecki un sportisti Noā Lailss un Elisona Fēliksa bija brīvprātīgo vidū šajā projektā.
"Mēs par to esam runājuši un vairākus mēnešus esam strādājuši pie sistēmas ieviešanas," laikrakstam sacīja Tigarts. "Covid-19 to sekmēja."
Ledecki sacīja, ka viņa "jutās ļoti ērti", veicot savu pirmo pašpārbaudi šonedēļ savās mājās Kalifornijā.
USADA sistēmā ir paredzēti drošības pasākumi, lai ierobežotu krāpšanās iespējas.
Lai arī sportisti urīna analīžu nodošanas laikā netiek novēroti, viņi uzrāda kontrolierim savu vannas istabu, kurā tiks ņemtas analīzes, sportistiem ir noteikts laiks, kā arī tiek mērīta parauga temperatūra, lai mazinātu parauga viltošanas vai aizstāšanas iespējas.